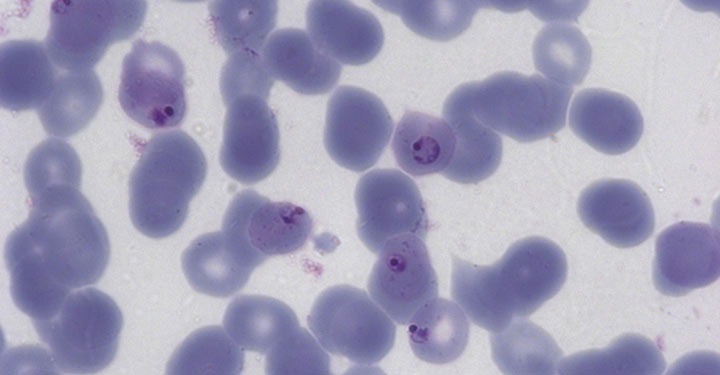

Study raises hope for new malaria treatments
Posted on 6 January 2015
New treatments for malaria could be a step closer following a study which has identified a way to stop malaria parasites from multiplying.
The research... has given fundamental insights into how malaria parasites function.”
The research team, which includes experts from the York Structural Biology Laboratory (YSBL), discovered the activity of an enzyme called NMT is essential for the survival and viability of the most common malaria parasite. Now the team is working to design molecules that inhibit the function of the enzyme and hope to start trials of potential treatments.
New drug target
Professor Tony Wilkinson of YSBL said: “The project has blended imaginative medicinal and analytical chemistry with protein crystallography and cell biology to define a new drug target in the fight against malaria, a major cause of human disease. While the research was targeted strategically towards drug discovery, it has given fundamental insights into how malaria parasites function.”
The new study shows that NMT is involved in a wide range of essential processes in the parasite cell, including the production of proteins that enable malaria to be transmitted between humans and mosquitoes and proteins that enable malaria to cause long-term infection.
Dr Ed Tate from the Department of Chemistry at Imperial College London, who led the project, said: “Here, we’ve shown not only why NMT is essential for a wide range of important processes in the parasite, but also that we can design molecules that stop it from working during infection. It has so many functions that we think blocking it could be effective at preventing long-term disease and transmission, in addition to treating acute malaria.
Clinical trials
“We need to do some more work in the lab to find the best candidate molecule to take into clinical trials, but hopefully we’ll be ready to do that within a few years.”
An estimated 1.2 million people died from malaria in 2010. Although a variety of antimalarial drugs are available, some strains of the parasite are resistant to treatment.
The discovery is the culmination of a five-year project by a consortium of researchers from Imperial College London, the National Institute for Medical Research, the University of Nottingham, the University of York, and Pfizer. The project was funded by the Medical Research Council, the Engineering and Physical Sciences Research Council, and the Biotechnology and Biological Sciences Research Council.
The text of this article is licensed under a Creative Commons Licence. You're free to republish it, as long as you link back to this page and credit us.

Tony Wilkinson
Research Title: Professor in the Department of Chemistry
Professor Wilkinson uses structural biology as a key tool to dissect structure and mechanism in proteins.
Discover the details
Find out more in the York Research Database
Article
- Validation of N-myristoyltransferase as an antimalarial drug target using an integrated chemical biology approach (Nature Chemistry)
Visit the departments
Explore more research

A research project needed to spot trees on historic ordnance survey maps, so colleagues in computer science found a solution.

We’re using gaming technology to ensure prospective teachers are fully prepared for their careers.

A low cost, high-accuracy device, could play a large part in the NHS's 'virtual wards'.
Research newsletter
Our monthly research newsletter features a curated mix of news, events, and recent discoveries delivered straight to your inbox.
